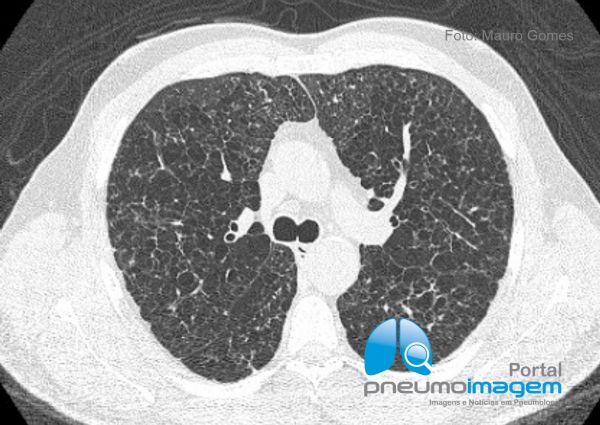

Comprometimento pulmonar da Histiocitose de Células de Langerhans caracterizado por pequenos cistos arredondados de paredes finas, bilaterais, de distribuição difusa e homogênea pelas regiões centrais e periféricas dos pulmões. Ainda há espessamento de septos interlobulares e discretas áreas em vidro fosco.
*****
Pulmonary involvement of Langerhans cell Histiocytosis characterized by small round, thin-walled, bilateral cysts of diffuse and homogeneous distribution through the central and peripheral regions of the lungs. There is still thickening of interlobular septa and discrete ground glass opacities.
O achado mais frequente na Histiocitose de Células de Langherans são os cistos pulmonares, geralmente pequenos, mas que também podem assumir tamanhos variados. Em algumas situações as paredes dos cistos podem ser espessas e irregulares, o que não ocorreu nesse caso. A associação com nódulos pulmonares varia de acordo com a fase de evolução da doença (fases mais precoces) e esse achado auxilia na suspeita diagnóstica.
*****
The most common finding in Langherans cell histiocytosis is pulmonary cysts, usually small but can also assume varying sizes. In some situations the walls of the cysts may be thick and irregular, which did not occur in this case. The association with pulmonary nodules varies according to the stage of evolution of the disease (earlier stages) and this finding helps in the diagnostic suspicion.

A Histiocitose de Células de Langerhans, previamente conhecida como Histiocitose X ou granuloma eosinofílico, é uma doença rara, de causa desconhecida, apesar de diversas evidências sugerirem origem imunológica. É caracterizada pela infiltração de células de Langerhans em diversos órgãos, possui um predomínio adultos jovens e fumantes. Lesões extrapulmonares, principalmente lesões ósseas líticas, podem ser observadas em associação às alterações pulmonares.
*****
Histocytosis of Langerhans Cells, previously known as Histiocytosis X or eosinophilic granuloma, is a rare disease, of unknown cause, although several evidences suggest immunological origin. It is characterized by the infiltration of Langerhans cells into various organs and has a predominance of young adults and smokers. Extrapulmonary lesions, mainly lithic bone lesions, may be observed in association with pulmonary alterations.
DEIXE SEU COMENTÁRIO